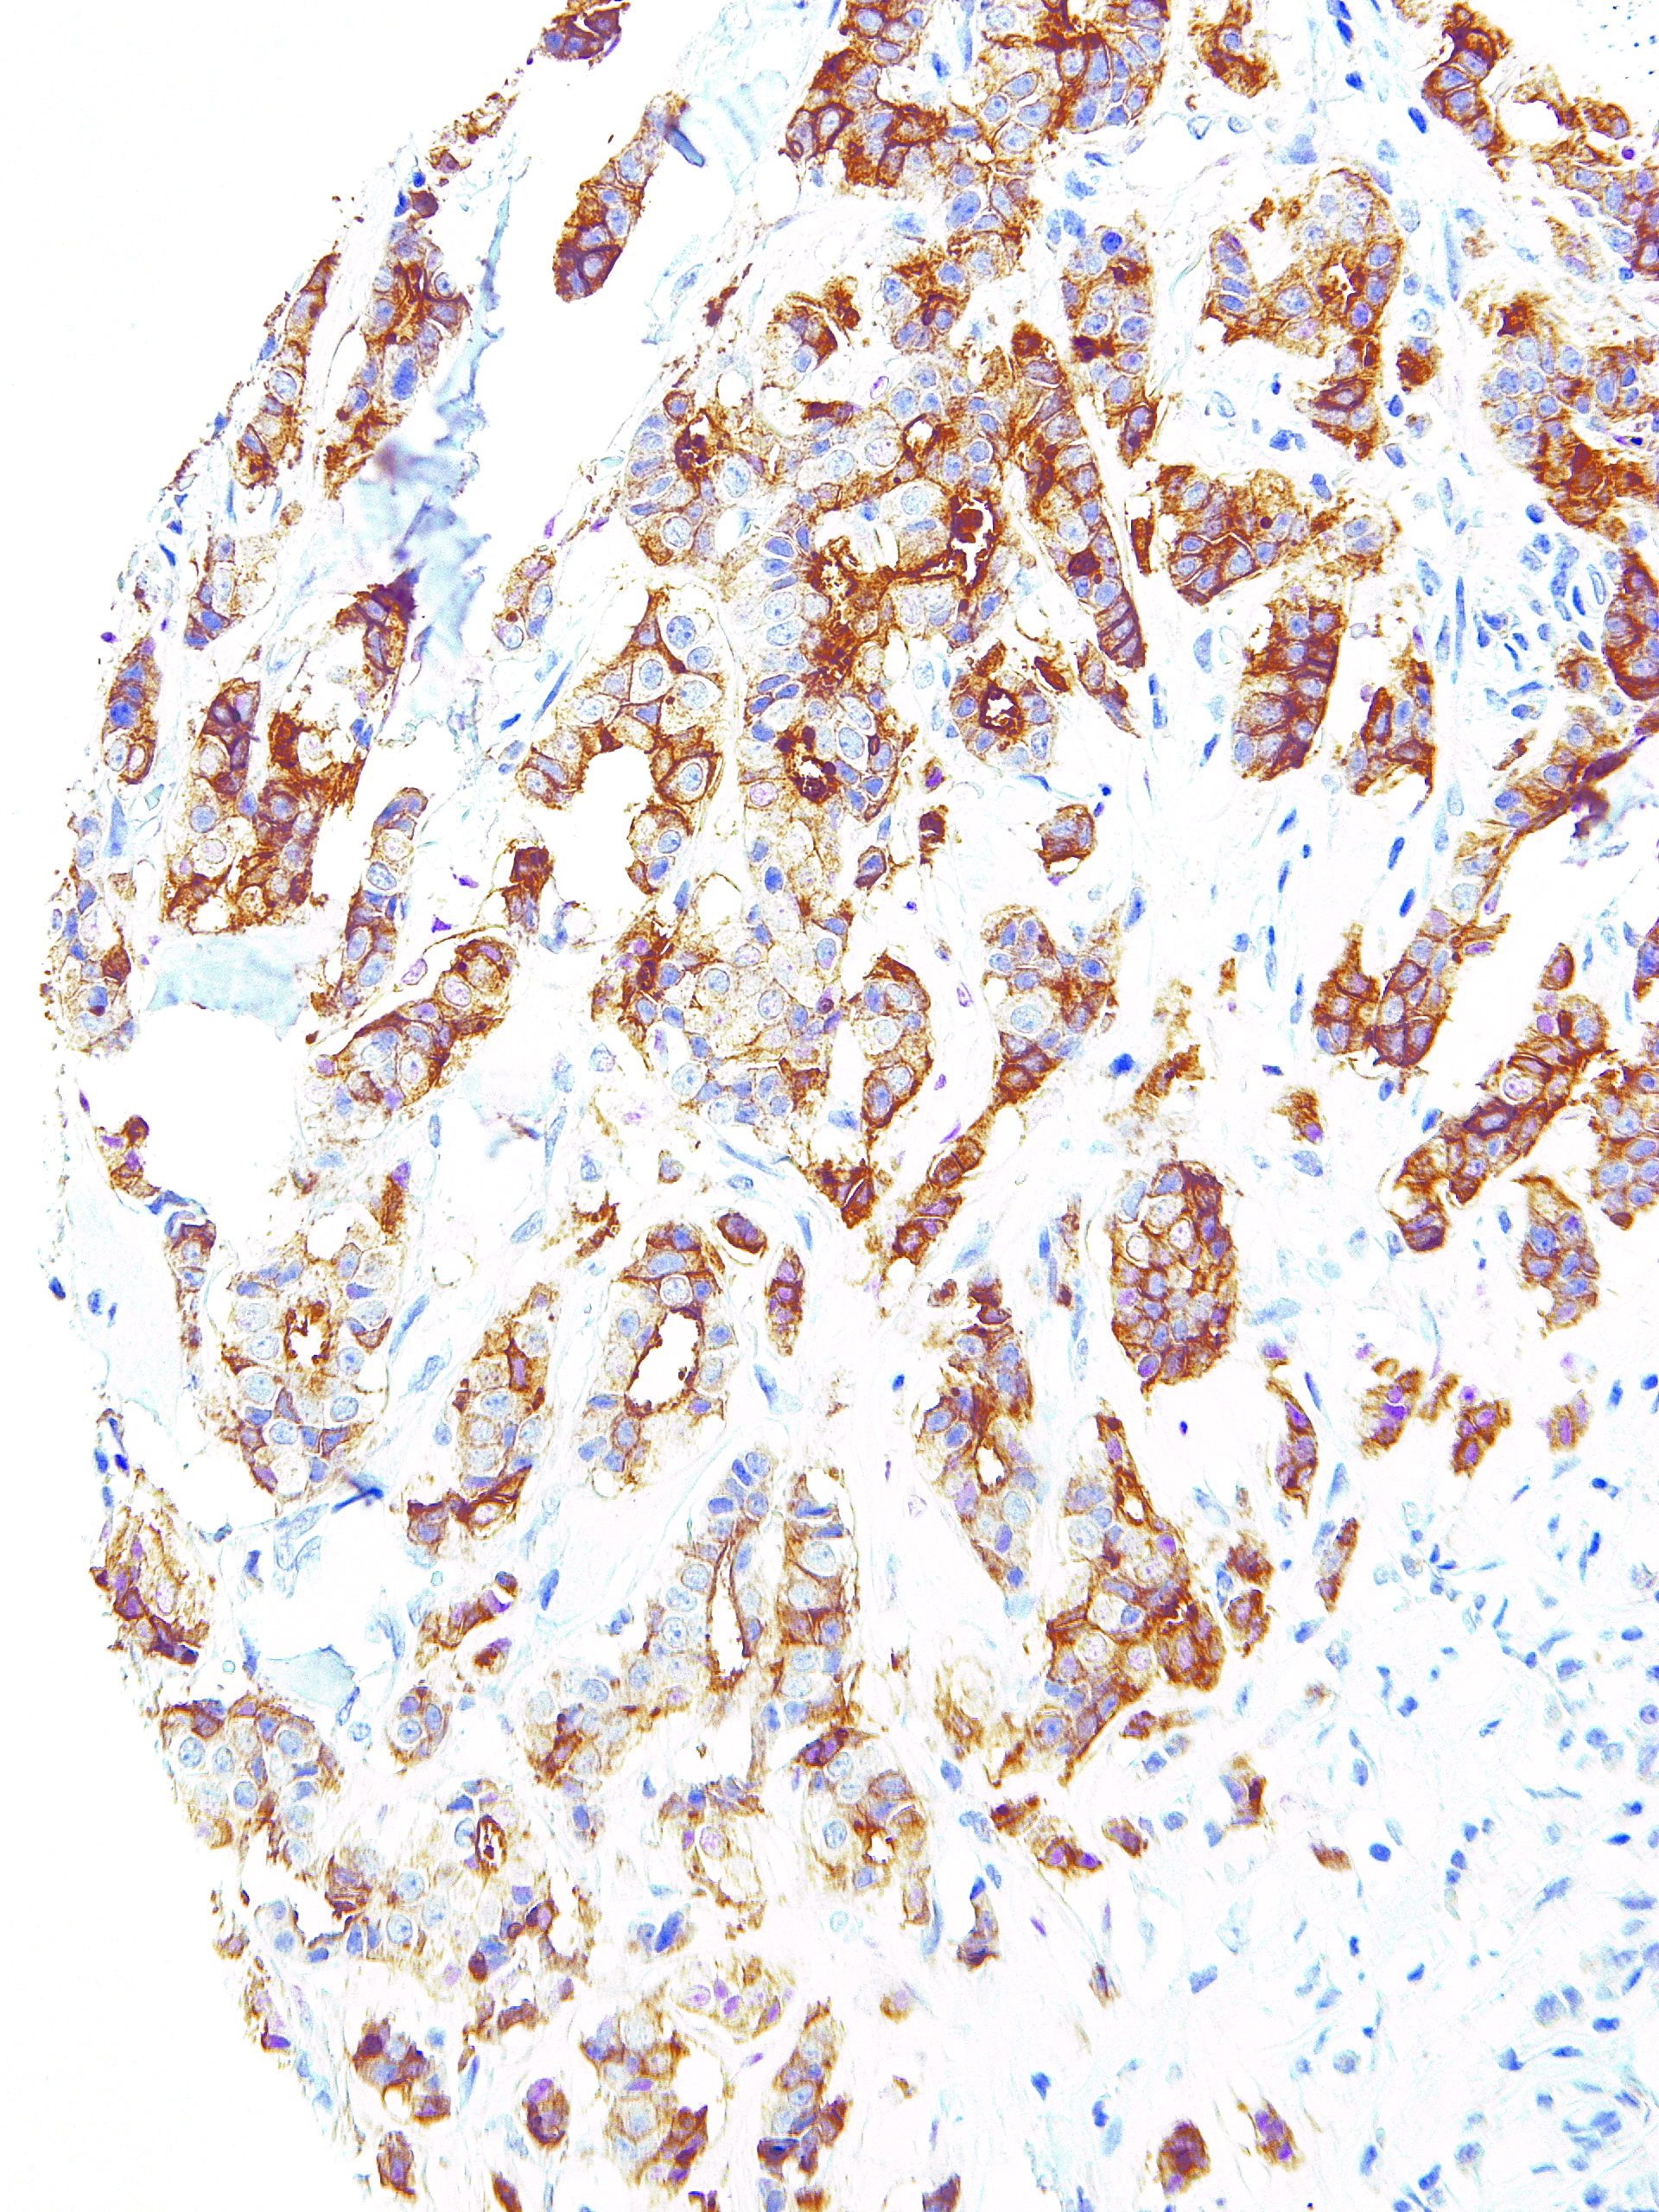

[Genomeme] B7-H4
CAT. NO. IHC104-100
Specifications
CLONE:
IHC104
ISOTYPE:
IgG2b
HOST SPECIES:
Mouse
CLONALITY:
Monoclonal
POSITIVE CONTROL:
Breast
DILUTION RANGE:
INTENDED USE/REG. STATUS:
RUO
Description
B7-H4 is a glycosylated transmembrane protein of the B7 family. It binds to activated T cells to moderate the T cell responses via cell cycle arrest in the T cell. Reverse signaling can induce either cell cycle arrest or apoptosis in the B7-H4 expressing cell. B7-H4 is up-regulated in several carcinomas in correlation with tumor progression and metastasis. A soluble form of B7-H4 is elevated in the serum of ovarian cancer, renal cell carcinoma, and rheumatoid arthritis patients, also in correlation with advanced disease status.
'Genomeme' 카테고리의 다른 글
| [Genomeme] BRAF V600E (0) | 2022.01.24 |
|---|---|
| [Genomeme] AKR1B10 (0) | 2022.01.13 |
| [Genomeme] CD23 (0) | 2021.09.24 |
| [Genomeme] BCL6 (0) | 2021.09.09 |
| [Genomeme] Helicobacter pylori (0) | 2021.08.11 |